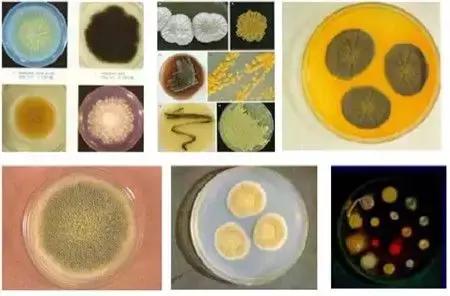
饲料霉菌毒素检测方法标准,常用饲料原料中霉菌毒素风险

霉菌毒素的来源、危害及限量标准
◆ 2010年-2017年中国生猪的出栏量

◆ 2010年-2017年中国配合饲料生产量

◆ 霉菌毒素污染所带来的经济损失
近年来,霉菌毒素的污染对农业和畜牧业生产造成了巨大经济损失,仅烟曲霉毒素每年对亚洲养猪业造成的经济损失可能高达11亿美元。据联合国粮食与农业组织(FAO)统计,全球每年约有25%的农作物被霉菌毒素污染,约2%的农作物因污染严重而失去营养和经济价值,造成数百亿美元的经济损失。

◆ 饲料中霉菌毒素污染情况
目前,全世界饲料业和养殖业都面临着饲料原料或者动物日粮霉菌毒素污染的困扰。随着全球异常气候的频发,以及全球谷物贸易的日益频繁,在动物配合饲料中常常有来自不同地域的谷物,大大增加了饲料受多种霉菌毒素污染的风险。

◆ 霉菌毒素污染的全球分布
全球谷物饲料中霉菌毒素污染都十分普遍和严重。各类原料和饲料、各个地区、各个季节均有霉菌毒素污染,检出率可高达70%~100%,按照饲料卫生标准判定的毒素超标率可达20%~80%。污染饲料的检出毒素少者2~3种,多者7~8种,呈现多种霉菌毒素复合污染的特征。

◆ 霉菌毒素的来源
自然界霉菌种类极多,约12万种,其中能产生霉菌毒素的有170余种,广泛存在于土壤空气水及腐败有机物中,遍及全世界。霉菌毒素约有300多种,主要由四种霉菌属产生:曲霉菌属(主要分泌黄曲霉毒素、赭曲霉毒素等)、青霉菌属(主要分泌桔霉素等)麦角菌属(主要分泌麦角毒素)、梭菌属(主要分泌呕吐毒素、玉米赤霉烯酮、T-2毒素、伏马镰孢毒素等)。

◆ 收获前霉菌毒素的污染
任何生长中的农作物,包括饲草和谷物等,都容易受到霉菌的污染同时产生霉菌毒素。霉菌在随农作物由田间向饲料加工厂再向饲料槽的转换过程中,可能不会存活下来,但是霉菌毒素却完整地保留了下来。
饲料原料看上去颜色外观都不错,常规指标检测分析结果也不错。但往往就是这些不错的原料很可能早就已经成为霉菌毒素的“避风港”了。

◆ 收获后霉菌毒素的污染
收获后的农作物,如果在贮存、运输、加工、保藏的过程中,外环境满足霉菌的生长需求,霉菌是会继续生长产毒。此时霉菌毒素会一直积累叠加,最终危害动物机体而不自知。曲霉菌 (Aspergillu) 和青霉菌 (Penicillium)是作物收获后导致作物霉变危害最大的霉菌。

◆ 谷物及饲料中主要产毒霉菌及其霉菌毒素

◆ 霉菌毒素的特性
一、高效性
很低的浓度即能产生明显的毒性(μg/kg)。在污染比较严重的几种霉菌毒素当中,黄曲霉毒素 B1(AFB1) 是具有很强毒性的一种毒素,其毒性是氰化钾的 10 倍,*霜砒**的68 倍,被世界卫生组织的肿瘤研究机构(IARC)列为Ⅰ类致癌物质。
二、高稳定性
低分子化合物,非常稳定,可耐高温。黄曲霉毒素具有比较稳定的化学性质,只有在 280℃以上高温下才能被破坏,对热不敏感,100℃ /20h 也不能将其完全去除。
三、富集性
抗化学生物制剂及物理的灭能作用,可以在生物链中不断传播、富集。原本被分泌及污染而残留在土壤中的霉菌毒素会被后来种植的谷物所吸收,从而引起更多霉菌毒素污染及感染的问题。
四、特异性
分子结构不同,毒性相差很大。如黄曲霉毒素族有黄曲霉毒素 B1、B2、M1、M2,毒性均不一样。
五、相加协同效应
霉菌毒素之间相互作用: 霉菌毒素的相乘作用,饲料或原料中往往不止含一种毒素,至少含有2种以上。两种或两种以上的毒素在一起产生的毒性作用比任何一种毒素单独产生的毒性都大 ,即当多种毒素同时存在时,不同毒素的毒性会增加,呈现协同或增加的现象 ,不同原料配制而成的全价料会有不同的毒素混合污染,毒素间的协同作用将会导致毒力大大增强,给畜禽带来巨大的危害。
多种霉菌毒素危害的叠加效应表

六、污染地域性
动物饲料及农产品中霉菌毒素的产生具有一定的地域性。例如,热带和亚热带区域是曲霉菌生长的最佳环境。尽管如此,饲料和农产品贸易的全球化导致霉菌毒素在全世界范围内传播。

七、隐蔽性
霉菌毒素检测时也常受到小分子物质(糖苷、葡糖苷酸、脂肪酸酯和蛋白质 ) 的掩盖,这些小分子物质与霉菌毒素结合在一起,导致检测值为错误的阴性结果。最终,这些被掩盖的霉菌毒素不能被传统的分析方法所检测。但这些结合到霉菌毒素上的分子可能在消化过程中被解除,从而释放出霉菌毒素,危害动物健康。

◆ 常见霉菌毒素的污染基质及危害

◆ 霉菌毒素对猪和牛的危害

◆ 霉菌毒素对动物机体的致病模式

◆ 新饲料卫生标准中黄曲霉毒素B1的限量标准

◆ 新饲料卫生标准中玉米赤霉烯酮的限量标准

◆ 新饲料卫生标准中呕吐毒素的限量标准

◆ 新饲料卫生标准中赭曲霉毒素A的限量标准

◆ 新饲料卫生标准中T-2毒素的限量标准

◆ 新饲料卫生标准中伏马菌素的限量标准

霉菌毒素常用检测方法介绍与对比
◆ 霉菌毒素常用检测方法

► 薄层色谱法
该方法目前已基本退出呕吐毒素检测的历史舞台!

► 仪器分析方法(HPLC/HPLC-MS)
本方法主要用于可疑样本、疑似阳性样本的最终确证和法检。

► 酶联免疫分析方法(ELISA)
本方法为传统快检方法,应用非常广泛,但随着快速定量检测试纸技术的成熟和普及,正被快速替代。

► 胶体金免疫层析法
本方法应用非常广泛,主要用于样品的初筛,结果以定性或半定量为主。

► 荧光定量免疫层析法
本方法为上海飞测生物率先在真菌毒素检测领域推出,因其快速简便准确定量的优点,正快速替代胶体金试纸条和酶免试剂盒等传统快检产品,实现快检方法从粗略定性到准确定量的升级换代。

◆ 不同方法学性能对比

◆ 真菌毒素检测如何正确抽样
真菌毒素的检测误差一直是粮油、饲料等领域令检验化验人员非常头疼的问题,有时甚至会达到百分之几百的偏差,误差的来源和影响因素非常之多,如检测产品本身、操作流程和细节掌握程度、实验环境和条件、不同种类样品的基质效应等,其中影响最大的一个因素--抽样。

◆ 抽样的关键性
1、真菌毒素在样品中的分布是不均匀的
下图以蛋白质和真菌毒素在样品中的分布情况向我们表明真菌毒素分布的及其不均匀性。

2、真菌毒素检测的精度都在ppb级别
ppb即10亿分之一,是一个非常微量的单位,没有足够的抽样量,会造成很大的误差影响。下表为美国农业部提供的信息,在一卡车玉米中加标20ppb的黄曲霉毒素污染情况。

◆ 抽样注意事项
1、抽样的原则
由于真菌毒素分布的随机性,抽样的时候要做到多点、随机、均匀,使得每个部位都有相同的概率被取到。
2、抽样的数量
FAO和WTO建议没200公斤物料抽样一次,如果所抽样品是混合比较均匀的粉状物料,可以适当的减少抽样点数。在实际工作中由于人力、物力有限,所以在实际操作中抽样点数应根据企业实际情况以及物料情况来确定抽样点数。
3、抽样量
原料送检样品抽样成品可在500g,原料样品在1000g,这样可以保证检测的最低检测量和检测样品的霉菌毒素的分布均一性。
上海飞测荧光定量快速检测方法介绍
◆ 免疫学快速检测的发展历程
上海飞测生物自主开发的基于荧光纳米微球的时间分辨荧光快速定量检测技术平台,因其具有灵敏度高、定量范围宽、准确度和精密度高、稳定性强、操作快速简便等优点,被业界誉为*四代第**荧光定量免疫层析技术中“皇冠上的明珠”,正快速替代胶体金试纸条和酶联免疫试剂盒等传统快速检测产品,引领真菌毒素快速检测从粗略定性到准确定量的升级换代。

◆ 上海飞测荧光定量FPOCT快速检测技术平台

◆ 检测原理
当将样品滴加在加样区时,样品中的待测物与结合垫中的荧光微球标记抗体结合并通过毛细作用向前层析,当 达到检测区后,检测线T线上固定的抗原与剩余的部分荧光微球标记抗体结合,检测线T线上结合的荧光微球标记抗体的量与样品中待测物的量成反比,质控线C线结合的荧光标记物样品中待测物的量无关,其它荧光标记物继续层析达到吸收区。层析结束后,采用荧光读数仪的读取T线和C线的荧光强度并计算T/C值,通过仪器内置的标准曲线即可计算出 样品中待测物的含量。

◆ Microdetection系列荧光微球
Microdetection®系列荧光微球采用聚苯乙烯纳米微球对*土稀**荧光离子铕进行包裹,通过荧光预增强技术,提升单个荧光离子的荧光强度。通过对包裹技术的优化和改良,纳米微球中铕离子的密度可提升到10万个/微球,包裹完荧光离子后,在微球表面再进行葡聚糖修饰,大大提升了微球的稳定性和对可逆环境的抗干扰性。在此基础上可开发出灵敏度高于普通胶体金或有色乳胶免疫层析方法2-3个数量级的定量检测技术。

◆ 荧光染料*土稀**元素铕的特点

◆ 双T线定量检测技术
目前,普通免疫层析快检产品通常采用单检测线(T线)定量方法,产品研发周期更短,生产工艺更为简单,成本也更低,但检测结果的精密度难以控制,导致结果的重复性较差。我们在单T线的基础上,增加了一条矫正T线,与质控线(C线)一起,形成“双保险”,大大提升了检测结果的精密度和重复性。

◆ 溯源管理云平台
为满足集团公司或政府监管部门对各个子公司或下级单位检测数据的信息化、智能化管理需求,上海飞测开发了基于阿里云的溯源管理云平台。检测仪内置GPRS无线通信模块(可自主选择打开或关闭),开通该功能后,检测信息和结果可实时上传云平台,实现仪器端、电脑端和手机端的数据同步共享,通过云平台可实现检测结果分析、质量安全溯源、安全预警、全过程质量控制、系统远程更新、标准曲线*载下**、功能权限设置等功能,既满足了检测信息和数据的智能化网络化管理,又确保了检测数据的安全可控。

◆ FD-100型霉菌毒素快速检测仪(经典版)

功能:
可快速准确定量的测定出饲料原料及饲料成品中真菌毒素的具体含量,包括黄曲霉毒素、玉米赤霉烯酮、呕吐毒素、赭曲霉毒素、伏马菌素、T-2毒素等;
特点:
1、仪器小巧便携,操作简便,易学易会;
2、结果准确可靠,稳定性和重复性好;
3、经济实惠,好用还不贵;
◆ FD-600型霉菌毒素快速检测仪(升级版)

◆ 霉菌毒素荧光定量快检箱--现场检测

◆ 上海飞测呕吐毒素荧光定量快速检测产品优势

➣方法领先:国内首个食品安全FPOCT荧光定量快速检测技术平台,引领行业方向;
➣升级换代:替代胶体金和酶联免疫传统快检方法,实现从粗略定性到准确定量的升级换代;
➣ 快速简便:一步加样,8min出定量结果,极简的操作,让检测过程不再繁琐;
➣ 准确定量:基于荧光纳米微球定量原理,结果高度符合国标法,稳定可靠;
➣ 随到随检:无需使用标准品,无需做标准曲线,样品随到随检,现场出定量结果;
➣ 联网溯源:检测数据和信息可实时传送云平台,实现检测数据的信息化、智能化管理需求;
➣ 权威验证:以优异成绩国粮局及农科院质量标准研究所验证和评审;
➣ 安全环保:操作人员不接触标准品,检测卡封闭设计,避免对操作人员可能的伤害;
➣ 小巧便携:检测仪器小巧便携,既可用于实验室检测,也可用于原粮收购现场检测;
➣ 经济实惠:取代胶体金试纸条和酶免试剂盒,获得国标法的准确结果,省时省力省钱;
◆ 上海飞测霉菌毒素荧光定量快速检测产品技术性能

◆ 检测样本适用范围

◆ 饲料成品及原料复杂样本专用检测试纸条

除玉米、小麦、高粱等简单原粮样品外,饲料领域还会涉及诸多复杂的样本,如复合饲料成品、饲料原料如DDGS、各种粕类、喷浆玉米皮、酱油糟、米糠、鱼粉、麸皮等,因其成分复杂、蛋白或脂肪含量偏高、有背景颜色、pH偏酸及其他影响因素,一般方法很难准确检测,假阳性现象尤其突出。
上海飞测生物基于荧光纳米微球的荧光定量FPOCT快速定量检测技术,因其特有的时间分辨荧光功能,很好的解决这些特殊样本的检测难题,推出了针对饲料领域复杂样品的专用试纸条,检测结果跟国标方法高度符合。
◆ 样品前处理过程
1、粉碎,称量;
2、加样品提取液提取(5min);
3、离心;

◆ 上样检测操作过程
1、稀释
2、加样,反应;
3、读数,打印检测报告;

◆ 国粮局粮科院验证报告

◆ 国粮局标准质量中心验证评审报告

◆ 山东省粮油检测中心和浙江省食药监局验证报告

◆ 中国农科院质量标准与检测技术研究所验证

◆ 申请专利及软著19项

◆ 已合作代表性客户

◆ 公司资质
